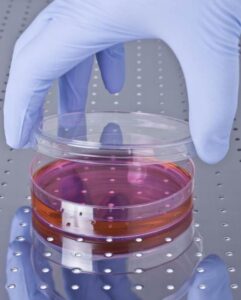
Hücresel Yenilenme Tedavisinin Hedeflediği Hastalıklar

Sağlık Turizmi
Hücresel Yenilenme Türkiye

Türkiye’de kök hücre tedavisi ile hücresel yenilenme: Bilimsel temeller, tedavi süreçleri, fiyatlar ve rejeneratif tıp hakkında kapsamlı rehber.
Türkiye’de Kök Hücre Tedavisi ile Hücresel Yenilenme: Bilimsel Temeller ve Uygulama Yöntemleri
Türkiye, son yıllarda rejeneratif tıp alanında kaydettiği ilerlemelerle dünya çapında dikkat çeken ülkeler arasında yer alıyor. Kök hücre tedavisi ve hücresel yenilenme teknolojileri, geleneksel tedavi yöntemlerinin yetersiz kaldığı durumlarda umut ışığı olarak ortaya çıkıyor. Bu devrim niteliğindeki tedavi yaklaşımı, hasarlı dokuları onarmak ve vücudun doğal iyileşme kapasitesini artırmak amacıyla kullanılıyor.

Türkiye’de Kök Hücre Tedavisi ile Hücresel Yenilenme
Kök Hücre Tedavisinin Bilimsel Temelleri ve Türkiye’deki Gelişim Süreci
Türkiye’de kök hücre araştırmaları 2000’li yılların başında hız kazanmış ve bugün dünya standartlarında tedavi protokolleri uygulanıyor. Mezenkimal kök hücreler, embriyonik kök hücreler ve indüklenmiş pluripotent kök hücreler olmak üzere farklı türlerdeki kök hücreler, çeşitli hastalıkların tedavisinde kullanılıyor.
Türk bilim insanları, özellikle otolog kök hücre tedavisi konusunda önemli başarılar elde etmiş durumda. Bu yöntemde hastanın kendi vücudundan elde edilen kök hücreler kullanıldığı için reddedilme riski minimum seviyede tutuluyor. Ülkemizdeki üniversite hastaneleri ve özel sağlık kuruluşları, uluslararası akreditasyon standartlarına uygun olarak bu tedavileri gerçekleştiriyor.
Kök hücre tedavisinin temel prensibi, hasarlı dokuların yerine sağlıklı hücrelerin üretilmesi ve vücudun doğal onarım mekanizmalarının desteklenmesi üzerine kuruludur. Bu süreçte, kök hücreler belirli sinyaller aracılığıyla ihtiyaç duyulan hücre tiplerine dönüşerek hasarlı bölgelerde yeniden yapılanma sağlıyor.
Hücresel Yenilenme Tedavisinin Uygulama Alanları ve Tedavi Protokolleri
Türkiye’de Longevity tedavisi geniş bir yelpazede uygulanıyor ve her geçen gün yeni endikasyonlar ekleniyor. Kardiyovasküler hastalıklardan ortopedik problemlere, nörolojik bozukluklardan dermatolojik uygulamalara kadar pek çok alanda başarılı sonuçlar elde ediliyor.
Hücresel yenilenme tedavisinin başlıca uygulama alanları şunlardır:
- Ortopedik Uygulamalar: Eklem kıkırdağı hasarları, menisküs yırtıkları, tendon ve ligament yaralanmaları
- Kardiyovasküler Tedaviler: Kalp yetmezliği, miyokard enfarktüsü sonrası doku onarımı
- Nörolojik Bozukluklar: Parkinson hastalığı, multiple skleroz, spinal kord yaralanmaları
- Dermatolojik Uygulamalar: Yaşlanma karşıtı tedaviler, saç dökülmesi, yara iyileşmesi
- Oftalmolojik Tedaviler: Makula dejenerasyonu, kornea hasarları
- Gastrointestinal Hastalıklar: Crohn hastalığı, karaciğer sirozu
Türkiye’deki tedavi merkezleri, minimal invaziv yöntemler kullanarak bu uygulamaları gerçekleştiriyor. Tedavi süreci genellikle hastanın kendi yağ dokusundan veya kemik iliğinden kök hücre eldesi ile başlıyor. Elde edilen hücreler özel laboratuvar koşullarında zenginleştirildikten sonra hedef bölgeye enjekte ediliyor.
Türkiye’deki Hücresel Yenilenme Tedavisinin Avantajları ve Gelecek Perspektifleri
Türkiye’de longevity tedavisi, hem maliyet avantajı hem de kaliteli hizmet sunması açısından uluslararası hastalarca tercih ediliyor. Ülkemizin bu alandaki başarısı, deneyimli uzman kadrosu, modern teknolojik altyapısı ve uygun fiyat politikaları sayesinde mümkün oluyor.
Türk sağlık sistemi, kök hücre tedavisi konusunda hasta güvenliğini ön planda tutarak titiz bir yaklaşım sergiliyor. Tedavi öncesi kapsamlı değerlendirme, uygun hasta seçimi ve tedavi sonrası takip süreçleri standardize edilmiş protokoller dahilinde yürütülüyor.
Gelecek dönemde, gen terapisi ile kombine edilen kök hücre uygulamaları, 3D biyobaskı teknolojisi ve organoid geliştirme çalışmaları Türkiye’de hız kazanacak. Bu gelişmeler, daha karmaşık hastalıkların tedavisinde yeni umutlar yaratacak.
Sonuç olarak, Türkiye’de hücresel yenilenme tedavisi alanında kaydedilen ilerlemeler, hastaların yaşam kalitesini artırırken, ülkemizi bu alanda öncü konuma taşıyor. Bilimsel araştırmalar ve klinik uygulamaların bir arada yürütülmesi, gelecekte daha da başarılı sonuçlar elde edilmesini sağlayacak.
Hücresel Yenilenme Tedavisinin Hedeflediği Hastalıklar ve Tedavi Amaçları: Kapsamlı Rehber
Hücresel Yenilenme Tedavisinin Hedeflediği Hastalıklar
Hücresel yenilenme tedavisi, geleneksel tıp yaklaşımlarının sınırlarını aşarak hastalıkların kökenine inen bir tedavi felsefesi sunuyor. Bu yaklaşım, sadece semptomları bastırmak yerine hasarlı dokuları köklü bir şekilde onarma ve vücudun doğal iyileşme potansiyelini maksimuma çıkarma amacı güdüyor. Türkiye’de bu alanda kaydedilen ilerlemeler, hastaların tedavi seçeneklerini genişletirken, tıp dünyasında da önemli bir paradigma değişiminin habercisi oluyor.
Günümüzde longevity tedavisinin hedeflediği hastalık spektrumu oldukça geniş bir yelpazeyi kapsıyor. Bu tedavi yöntemi, kronik dejeneratif hastalıklardan akut yaralanmalara, yaşa bağlı fonksiyon kayıplarından otoimmün bozukluklara kadar pek çok farklı sağlık problemi için umut vadediyor. Her bir hastalık grubu için özelleştirilmiş protokoller geliştirilmesi, tedavi başarısını artıran en önemli faktörlerden biri olarak öne çıkıyor.
Kronik Dejeneratif Hastalıklarda Hücresel Yenilenme: Yaşam Kalitesini Geri Kazanma
Kronik dejeneratif hastalıklar, geleneksel tedavi yöntemlerinin en zorlandığı alanlardan birini oluştururken, hücresel yenilenme tedavisi bu hastalıkların seyrini değiştirmede çığır açıcı bir potansiyel sergiliyor. Osteoartrit, romatoid artrit ve fibromiyalji gibi kas-iskelet sistemi hastalıklarında, hasarlı kıkırdak dokusunun yeniden inşası ve eklem fonksiyonlarının iyileştirilmesi mümkün hale geliyor.
Nörodejeneratif hastalıklarda ise hücresel yenilenme tedavisi, beyin dokusundaki nöron kaybını yavaşlatma ve mevcut nöral ağları güçlendirme yönünde etkileyici sonuçlar gösteriyor. Alzheimer hastalığı, Parkinson hastalığı ve multiple skleroz gibi durumlar için geliştirilen özel protokoller, hastalığın ilerleyişini durdurmaktan ziyade geriye doğru çevirme potansiyeli taşıyor. Bu tedavi yaklaşımında, nörotrofik faktörlerin artırılması ve sinaptik bağlantıların güçlendirilmesi temel hedefler arasında yer alıyor.
Kardiyovasküler hastalıklar alanında da longevity tedavisi devrim yaratıyor. Kalp krizi sonrası oluşan skar dokusunun yerine sağlıklı kalp kasının yeniden üretilmesi, kalp yetmezliği olan hastalarda yaşam süresini uzatmanın ötesinde yaşam kalitesini de dramatik şekilde iyileştiriyor. Miyokard dokusunun rejenerasyonu sayesinde, daha önce kalp nakli gerektiren durumlar bile alternatif tedavi seçenekleri kazanıyor.
Metabolik Bozukluklar ve Otoimmün Hastalıklarda Yenilikçi Yaklaşımlar
Metabolik hastalıklar konusunda hücresel yenilenme tedavisi, özellikle diyabet tedavisinde paradigma değiştirici bir etki yaratıyor. Tip 1 diyabette pankreas beta hücrelerinin yeniden üretilmesi ve Tip 2 diyabette insülin direncinin kırılması için geliştirilen protokoller, hastaların insülin bağımlılığını azaltma potansiyeli taşıyor. Bu yaklaşım, sadece kan şekeri kontrolü sağlamakla kalmayıp, diyabetin neden olduğu komplikasyonları da önleme yönünde etkili sonuçlar gösteriyor.
Otoimmün hastalıklarda ise hücresel yenilenme tedavisi, bağışıklık sisteminin yeniden programlanması yoluyla hastalığın kökünde bulunan otoimmün süreci durdurmayı hedefliyor. Sistemik lupus eritematosus, Crohn hastalığı ve psoriasis gibi durumlar için geliştirilen özel protokoller, immün sistemin hasarlı dokularına saldırısını durdururken, aynı zamanda bu dokuların onarımını da destekliyor.
Oftalmolojik hastalıklar alanında da longevity tedavisi önemli başarılar kaydediyor. Yaşa bağlı makula dejenerasyonu, diabetik retinopati ve kornea hasarları gibi durumlar için geliştirilen tedavi protokolleri, görme fonksiyonunun geri kazanılması konusunda umut verici sonuçlar sunuyor. Retinal pigment epitel hücrelerinin yenilenmesi ve fotoreseptör hücrelerin rejenerasyonu sayesinde, daha önce geri dönüşümsüz kabul edilen görme kayıpları bile tedavi edilebilir hale geliyor.
Yaşlanma Karşıtı Uygulamalar ve Estetik Tıpta Hücresel Yenilenme
Hücresel yenilenme tedavisinin en heyecan verici uygulamalarından biri de yaşlanma karşıtı tedaviler alanında görülüyor. Bu yaklaşım, sadece yaşlanmanın görünen etkilerini maskelemekle kalmayıp, hücresel düzeyde yaşlanma sürecini yavaşlatma ve hatta tersine çevirme potansiyeli taşıyor. Telomer uzunluğunun artırılması, mitokondriyal fonksiyonların iyileştirilmesi ve hücresel senescence’ın önlenmesi gibi mekanizmalar üzerinden yaşlanma sürecine müdahale ediliyor.
Dermatolojik uygulamalarda hücresel yenilenme tedavisi, cilt yaşlanması, saç dökülmesi ve çeşitli cilt hastalıklarının tedavisinde çok boyutlu bir yaklaşım sunuyor. Fibroblast aktivasyonu, kollajen sentezinin artırılması ve dermal matriks yenilenmesi sayesinde cildin doğal gençlik görünümü geri kazanılıyor. Bu süreçte, sadece yüzeysel düzeltmeler yapılmakla kalmayıp, cildin altta yatan yapısal sorunları da çözümleniyor.
Üreme sağlığı alanında da longevity tedavisi devrim yaratıyor. İnfertilite problemleri, menopoz semptomları ve üreme organlarındaki fonksiyon bozuklukları için geliştirilen protokoller, doğal üreme kapasitesinin restore edilmesi konusunda başarılı sonuçlar veriyor. Ovarian rejenerasyon ve endometrial yenilenme gibi yaklaşımlar, daha önce tedavisi mümkün olmayan durumlar için yeni umutlar yaratıyor.
Sonuç olarak, hücresel yenilenme tedavisinin hedeflediği hastalık yelpazesi sürekli genişlerken, her bir endikasyon için özelleştirilmiş tedavi protokolleri geliştirilmesi bu alanın geleceğini şekillendiriyor. Türkiye’nin bu konudaki artan uzmanlığı ve teknolojik altyapısı, hem yerli hem de uluslararası hastalar için güvenilir ve etkili tedavi seçenekleri sunmaya devam ediyor.
Türkiye’de Hücresel Yenilenme Tedavisi: Maliyet Analizi, Süreç Aşamaları ve Klinik Seçimi

Türkiye’de Hücresel Yenilenme Tedavisi: Maliyet Analizi, Süreç Aşamaları ve Klinik Seçimi
Türkiye’de hücresel yenilenme tedavisi alanında yaşanan hızlı gelişmeler, hastaların bu yenilikçi tedavi seçeneğine erişimini kolaylaştırırken, aynı zamanda tedavi maliyetleri ve süreç yönetimi konularında detaylı bilgi ihtiyacını da beraberinde getiriyor. Modern tıbbın en ileri teknolojilerini kullanan bu tedavi yaklaşımı, sadece tıbbi başarı açısından değil, ekonomik açıdan da dikkatli bir planlama gerektiriyor. Hastalar için en kritik konulardan biri, tedavi sürecinin başından sonuna kadar karşılaşacakları maliyetleri öngörebilmek ve uygun klinik seçimi yapabilmek oluyor.
Türkiye’deki hücresel yenilenme tedavisi pazarı, hem yerli hem de uluslararası hastalar için cazip fiyat avantajları sunarken, kalite standartlarından ödün vermeme ilkesiyle hareket ediyor. Bu denge, ülkemizi bu alanda tercih edilen bir destinasyon haline getirirken, hastalar için de önemli fırsatlar yaratıyor. Ancak, tedavi sürecinin karmaşık yapısı ve kişiselleştirilmiş yaklaşım gerektirmesi, maliyet hesaplamalarını ve klinik seçimini zorlaştıran faktörler arasında yer alıyor.
Hücresel Yenilenme Tedavisinde Maliyet Bileşenleri ve Finansal Planlama Stratejileri
Türkiye’deki hücresel yenilenme tedavisi maliyetleri, tedavi türü, hasta profili ve seçilen klinik gibi birçok faktöre bağlı olarak değişkenlik gösteriyor. Temel maliyet bileşenleri arasında laboratuvar testleri, kök hücre izolasyonu ve kültürlenmesi, tedavi uygulaması ve takip süreçleri yer alırken, her bir aşamanın kendine özgü fiyat dinamikleri bulunuyor. Otolog kök hücre tedavisinde hastanın kendi dokularından hücre eldesi maliyeti, allojenik tedavilere göre daha ekonomik seyrederken, tedavi başarısı açısından da daha güvenli sonuçlar sunuyor.
Finansal planlama sürecinde hastalar, tedavi öncesi değerlendirme maliyetlerini de hesaba katmak zorunda kalıyor. Kapsamlı kan testleri, görüntüleme yöntemleri ve uzman konsültasyonları gibi ön değerlendirme aşamaları, toplam tedavi bütçesinin önemli bir kısmını oluştururken, bu yatırımın tedavi başarısı açısından kritik önemi bulunuyor. Türkiye’deki anlaşmalı klinikler genellikle paket fiyatlandırma yaklaşımını benimserken, bu durum hastaların bütçe planlamasını kolaylaştırıyor.
Uluslararası karşılaştırmalarda Türkiye’deki longevity tedavisi fiyatları, Avrupa ve Amerika’daki eşdeğer tedavilerin %40-60’ı oranında seyrediyor. Bu maliyet avantajı, sadece tedavi fiyatlarından kaynaklanmıyor; konaklama, ulaşım ve diğer yan hizmetlerdeki uygun fiyatlar da toplam tedavi maliyetini düşürüyor. Ancak, fiyat odaklı seçim yaparken kalite standartlarının göz ardı edilmemesi, uzun vadeli tedavi başarısı açısından hayati önem taşıyor.
Tedavi Sürecinin Aşamalı Yapısı ve Klinik Protokol Uygulamaları
Hücresel yenilenme tedavisi süreci, titizlikle planlanmış aşamalar halinde yürütülürken, her bir aşamanın kendine özgü gereksinimleri ve süre dinamikleri bulunuyor. İlk aşama olan ön değerlendirme süreci, hastanın genel sağlık durumunun belirlenmesi ve tedaviye uygunluğunun değerlendirilmesi amacıyla 3-5 gün sürebiliyor. Bu süreçte gerçekleştirilen detaylı laboratuvar analizleri, görüntüleme teknikleri ve uzman muayeneleri, kişiselleştirilmiş tedavi protokolünün temelini oluşturuyor.
Kök hücre eldesi ve işleme aşaması, tedavi sürecinin en kritik bölümlerinden birini oluştururken, bu süreç genellikle 1-2 gün içerisinde tamamlanıyor. Yağ dokusu veya kemik iliğinden elde edilen kök hücreler, özel laboratuvar koşullarında işlendikten sonra tedaviye hazır hale getiriliyor. GMP standartlarına uygun laboratuvar ortamında gerçekleştirilen bu işlemler, hücre kalitesi ve tedavi güvenliği açısından son derece önemli rol oynuyor.
Tedavi uygulaması aşaması, hastalığın türüne ve tedavi protokolüne bağlı olarak birkaç saat ile bir gün arasında değişen süreler alırken, bu süreçte hastanın konforlu bir ortamda tedaviyi alması sağlanıyor. İntravenöz, intra-artiküler veya lokal enjeksiyon yöntemleriyle uygulanan tedaviler, minimal invaziv yaklaşım benimserken, hastanın günlük yaşamına dönüş süresini de kısaltıyor. Takip ve kontrol aşaması ise 6-12 ay boyunca devam ederken, tedavi etkinliğinin objektif parametrelerle değerlendirilmesi mümkün oluyor.
Kaliteli Klinik Seçimi İçin Değerlendirme Kriterleri ve Karar Verme Süreci
Türkiye’de hücresel yenilenme tedavisi sunan klinik sayısının artmasıyla birlikte, doğru klinik seçimi kritik bir karar haline geliyor. Kaliteli bir klinik seçiminde öncelikle dikkate alınması gereken faktör, kliniğin sahip olduğu akreditasyonlar ve sertifikasyonlar oluyor. JCI, ISO 15189 ve GMP sertifikalarına sahip klinikler, uluslararası standartlarda hizmet verme kapasitesini kanıtlarken, hasta güvenliği açısından da güvence sağlıyor.
Uzman kadronun deneyimi ve akademik geçmişi, klinik seçiminde göz önünde bulundurulması gereken bir diğer önemli faktör olarak öne çıkıyor. Rejeneratif tıp alanında uzmanlaşmış hekimler, yayınları ve kongreye katılımları, tedavi başarı oranları gibi kriterler, kliniğin profesyonel kapasitesini değerlendirmek için kullanılabiliyor. Ayrıca, kliniğin sahip olduğu teknolojik altyapı, laboratuvar imkanları ve tedavi sonrası takip sistemleri de seçim sürecinde dikkate alınması gereken unsurlar arasında yer alıyor.
Hasta deneyimleri ve referanslar, klinik seçiminde objektif değerlendirme yapabilmek açısından değerli bilgi kaynakları sunuyor. Önceki hastaların tedavi süreçleri, memnuniyet düzeyleri ve elde ettikleri sonuçlar hakkında bilgi edinmek, karar verme sürecini destekleyici faktörler oluyor. Şeffaf fiyatlandırma politikası, detaylı bilgilendirme ve hasta hakları konusundaki yaklaşım da klinik kalitesini gösteren önemli göstergeler arasında sayılıyor.
Sonuç olarak, Türkiye’de hücresel yenilenme tedavisi alanında yaşanan gelişmeler, hastaların bu ileri teknoloji tedaviden faydalanma şansını artırırken, doğru klinik seçimi ve maliyet planlaması konularında bilinçli yaklaşım sergilemelerini gerektiriyor. Kaliteli ve güvenilir tedavi almak için yapılacak araştırma ve değerlendirme süreci, uzun vadeli tedavi başarısının anahtarını oluştururken, Türkiye’nin bu alandaki artan uzmanlığı hastaların lehine sonuçlar doğurmaya devam ediyor.
Rejeneratif Tıp ve Hücresel Tedavi Karşılaştırması: Hangisi Sizin İçin Doğru Seçim?
Rejeneratif tıp ve hücresel tedavi kavramları, modern sağlık hizmetlerinde sıklıkla birbirinin yerine kullanılmasına rağmen, aslında farklı kapsamlara sahip iki önemli tedavi yaklaşımını temsil ediyor. Türkiye’de bu alanda yaşanan hızlı gelişmeler, hastaların doğru tedavi seçimi yapabilmesi için bu yaklaşımların detaylı karşılaştırılmasını gerekli kılıyor. Her iki yöntem de vücudun doğal iyileşme kapasitesini desteklemeyi hedeflese de, uygulama yöntemleri, etki mekanizmaları ve tedavi sonuçları açısından önemli farklılıklar bulunuyor.
Modern tıp dünyasında yaşanan paradigma değişimi, geleneksel semptom odaklı tedavi yaklaşımlarından, hastalığın kökenine inen ve vücudun doğal onarım sistemlerini aktive eden yöntemlere doğru kaymaya devam ediyor. Bu dönüşümün merkezinde yer alan rejeneratif tıp ve longevity tedavi seçenekleri, hastalar için kişiselleştirilmiş çözümler sunarken, tedavi başarısının artırılması için doğru yöntem seçiminin kritik önemini ortaya koyuyor.
Rejeneratif Tıp: Kapsamlı Onarım ve Yeniden Yapılanma Yaklaşımı
Rejeneratif tıp, hasarlı dokuların tamamen yenilenmesi ve fonksiyonel kapasitelerinin restore edilmesi amacını güden geniş kapsamlı bir tedavi felsefesini benimsiyor. Bu yaklaşım, sadece kök hücre tedavisini değil, aynı zamanda doku mühendisliği, gen terapisi, büyüme faktörleri ve biyomateryal uygulamalarını da kapsayan multidisipliner bir alan oluşturuyor. Türkiye’deki rejeneratif tıp merkezleri, bu geniş spektrumlu yaklaşımı kullanarak karmaşık hastalıkların tedavisinde başarılı sonuçlar elde ediyor.
Rejeneratif tıbbın en karakteristik özelliği, hastalığın altında yatan nedenleri hedef alarak köklü çözümler üretmesi oluyor. Bu tedavi yaklaşımında, hasarlı organların fonksiyonel kapasitelerinin tamamen geri kazanılması hedeflenirken, vücudun doğal homeostaz mekanizmalarının yeniden kurulması da sağlanıyor. Özellikle yaşa bağlı dejeneratif değişiklikler, kronik hastalıklar ve travmatik yaralanmalar gibi durumlarda rejeneratif tıp uygulamaları, geleneksel tedavi yöntemlerinin ulaşamadığı başarı düzeylerini mümkün kılıyor.
Türkiye’deki rejeneratif tıp uygulamaları, kişiselleştirilmiş tedavi protokolleri geliştirme konusunda öncü role sahip. Her hastanın genetik profili, yaşam tarzı, hastalık geçmişi ve mevcut sağlık durumu detaylı analiz edilerek, en uygun rejeneratif tedavi kombinasyonu belirleniyor. Bu yaklaşım, tedavi etkinliğini maksimuma çıkarırken, yan etki risklerini de minimum seviyede tutuyor.
Hücresel Tedavi: Hedeflenmiş ve Spesifik Müdahale Stratejisi
Hücresel tedavi ise daha spesifik ve hedefe yönelik bir yaklaşım benimserken, öncelikli olarak kök hücre, trombositten zengin plazma (PRP) ve diğer hücresel komponenlerin kullanımına odaklanıyor. Bu yöntem, belirli doku tiplerindeki hasarların onarılması ve fonksiyonel iyileştirmelerin sağlanması amacıyla uygulanırken, daha sınırlı ama etkili bir tedavi spektrumu sunuyor. Türkiye’deki hücresel tedavi merkezleri, minimal invaziv yöntemlerle maksimum tedavi etkisi elde etme prensibiyle hareket ediyor.
Hücresel tedavinin temel avantajı, kısa sürede uygulanabilir olması ve hızlı sonuç vermesi oluyor. Özellikle akut yaralanmalar, eklem problemleri ve lokalize doku hasarlarında hücresel tedavi yaklaşımları, hastaların günlük yaşamlarına hızlı dönüş sağlamasını mümkün kılıyor. Bu tedavi yöntemi, hastanın kendi vücudundan elde edilen hücrelerle gerçekleştirildiği için biyouyumluluk açısından da üstün avantajlar sağlıyor.
Türkiye’de longevity uygulamaları, standart protokoller ve kanıta dayalı yaklaşımlar kullanılarak gerçekleştiriliyor. Tedavi süreci, hastanın durumuna göre özelleştirilen protokollerle yürütülürken, düzenli takip ve değerlendirme sistemi sayesinde tedavi etkinliği sürekli izleniyor. Bu yaklaşım, hem hasta güvenliği hem de tedavi başarısı açısından optimal sonuçlar elde edilmesini sağlıyor.
Doğru Tedavi Seçimi İçin Karar Verme Kriterleri ve Hasta Profili Analizi
Rejeneratif tıp ve hücresel tedavi arasında doğru seçim yapabilmek için hastanın bireysel durumu, hastalığın karakteristikleri ve tedavi hedefleri detaylı analiz edilmeli. Bu karar verme süreci, sadece tıbbi faktörleri değil, aynı zamanda hastanın yaşam kalitesi beklentilerini, zaman çizelgesini ve ekonomik durumunu da dikkate alacak şekilde planlanmalı. Türkiye’deki uzman hekimler, bu kapsamlı değerlendirme sürecini yürütürken, hastalarına en uygun tedavi yaklaşımını belirleme konusunda rehberlik ediyor.
Doğru tedavi seçimi için değerlendirilmesi gereken temel kriterler şu şekilde sıralanabilir:
- Hastalığın Şiddeti ve Yaygınlığı: Lokalize problemler için hücresel tedavi, sistemik durumlar için rejeneratif tıp yaklaşımı tercih ediliyor
- Tedavi Süresi Beklentisi: Hızlı sonuç isteyenler için hücresel tedavi, uzun vadeli çözüm arayanlar için rejeneratif tıp uygun oluyor
- Hastanın Yaşı ve Genel Sağlık Durumu: Genç hastalarda her iki yöntem de etkili olurken, ileri yaştaki hastalarda kişiselleştirilmiş yaklaşım gerekiyor
- Önceki Tedavi Deneyimleri: Geleneksel tedavilere yanıt vermeyen durumlar için rejeneratif tıp daha kapsamlı çözümler sunuyor
- Ekonomik Faktörler: Hücresel tedavi genellikle daha ekonomik olurken, rejeneratif tıp daha yüksek maliyet gerektiriyor
Türkiye’deki tedavi merkezleri, bu kriterlerin objektif değerlendirmesi için standart protokoller ve değerlendirme araçları kullanıyor. Hastanın tıbbi geçmişi, mevcut semptomları, fonksiyonel kapasitesi ve tedavi beklentileri detaylı analiz edilerek, en uygun tedavi yaklaşımı belirleniyor. Bu süreçte, multidisipliner ekip yaklaşımı benimsenirken, hastanın karar verme sürecine aktif katılımı sağlanıyor.
Sonuç olarak, rejeneratif tıp ve hücresel tedavi arasındaki seçim, hastanın bireysel ihtiyaçları ve tedavi hedefleri doğrultusunda yapılması gereken stratejik bir karar oluyor. Türkiye’nin bu alanda sahip olduğu deneyim ve teknolojik altyapı, hastalara her iki yaklaşım için de dünya standartlarında tedavi seçenekleri sunmaya devam ederken, doğru seçim yapabilmek için uzman görüşü almak kritik önem taşıyor.



